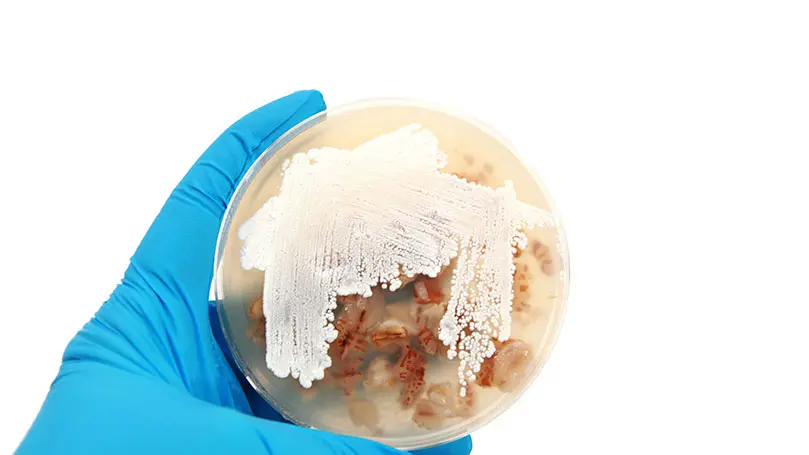
Hand in blauem Gummihandschuh hält Petrischale mit Stepromyces-Kolonie

In der Apotheke werden PTA mit den unterschiedlichsten Themen konfrontiert. Lesen Sie hier die tagesaktuellen News aus den Bereichen Pharmazie, Forschung, Ernährung, Gesundheit und vielem mehr. Bleiben Sie informiert, um Ihre Kunden stets kompetent zu beraten.
Zufall: Forschende entdecken potente Antibiotikum-Vorstufe
Neue Antibiotika werden dringend benötigt, die Zahlen resistenter und multiresistenter Erreger steigen weltweit an und werden zunehmend zu einer mitunter tödlichen Gefahr. Allerdings sind die Forschungsanstrengungen, neue Antibiotika zu finden, insbesondere seitens der Industrie eher zurückhaltend. Hohe Kosten bei auf der anderen Seite wahrscheinlich eher kleineren Erträgen bremsen das Engagement der Industrie.
Denn: Würde ein neues Antibiotikum kommerziell erfolgreich in großem Umfang eingesetzt, werden sich wahrscheinlich auch schnell Resistenzen bilden, die den Einsatz begrenzen. Und von vorneherein begrenzt einsetzbare Wirkstoffe bringen wohl nicht genug Profit.
Methylenomycin: ein Antibiotikum der Grundlagenforschung
Dies könnte auch einer der Gründe sein, warum sich eine bereits seit 1974 bekannte Antibiotika-Klasse bis heute hauptsächlich in Laboren findet: Die Cyclopentanon-Antibiotika Methylenomycin A und B sowie das Derivat Methylenomycin C.
Bis heute dienen diese Naturstoffe, die von Bodenbakterien der Gattung Streptomyces – genauer von Streptomyces coelicolor – produziert werden, vor allem Forschenden in der Grundlagenforschung. Wirksam sind die Antibiotika gegen Gram-positive und Gram-negative Bakterien. Ihre Wirkmechanismen sind allerdings bis heute nicht abschließend geklärt.
Auch wenn es bislang nicht eine klinische Studie zu diesen Wirkstoffen gibt und sie auch nach 50 Jahren das Stadium der Grundlagenforschung nicht überwunden haben, haben Forschende der Universitäten Warwick in Coventry, Großbritannien, und Monash in Melbourne, Australien jetzt für Schlagzeilen mit Methylenomycin gesorgt.
„Super-Antibiotikum“ gegen „Superbakterien“?
Unter anderem das renommierte Fachmagazin „Nature“ berichtete über ein „leistungsstarkes neues Antibiotikum, das Superbakterien abtöten kann“. Dabei war das nicht die ursprüngliche Intention der Forschenden. Eigentlich wollten sie den Biosyntheseweg der bekannten Antibiotika aufklären, indem sie die Gene verschiedener daran beteiligter Enzyme selektiv ausschalteten.
Dabei erhielten sie verschiedene Zwischenprodukte des Biosynthesewegs, die sich ohne die weiterprozessierenden Enzyme anreicherten. Eines davon war Prämethylenomycin C, welches sich schnell selbstständig in seine Lacton-Form, das Prämethylenomycin C-Lacton, zyklisiert.
Als die Forschenden routinemäßig die Zwischenprodukte auf ihre biologische Wirksamkeit hin überprüften, stellten sie fest, „dass sowohl Prämethylenomycin C als auch sein Lacton-Vorläufer gegenüber verschiedenen grampositiven Bakterien, darunter antibiotikaresistente Staphylococcus-aureus- und Enterococcus-faecium-Isolate, um ein bis zwei Größenordnungen wirksamer waren als Methylenomycin A und C. Dies bietet einen vielversprechenden Ausgangspunkt für die Entwicklung neuartiger Antibiotika zur Bekämpfung von Antibiotikaresistenzen“, schreiben die Autoren. Ihre Ergebnisse veröffentlichten sie im Fachmedium „Journal of the American Chemical Society“.
Auch gegen Candida albicans zeigte sich eine starke Wirkung bei den Tests auf antimikrobielle Aktivität.
Streptomyces coelicolor: Vom starken zum schwachen Antibiotikum entwickelt
Die Forschenden untersuchten auch exemplarisch an Enterococcus faecium im Vergleich mit Vancomycin, ob die Erreger Resistenzen gegen Prämethylenomycin-C-Lacton entwickeln können. Dabei kamen sie zu dem Schluss, dass dies jedenfalls bei Enterococcus faecium wohl erschwert sei.
„Es sieht so aus, als hätte Streptomyces coelicolor ursprünglich ein starkes Antibiotikum (Prämethylenomycin-C-Lacton) produziert, aber im Laufe der Zeit hat es sich zu Methylenomycin A verändert – einem viel schwächeren Antibiotikum, das möglicherweise eine andere Rolle in der Biologie des Bakteriums spielt“, bietet Dr. Lona Alkhalaf, Assistenz-Professorin an der Warwick-Universität und Co-Autorin der Arbeit, einen Erklärungsansatz.
Zwischenprodukte auf antimikrobielle Wirkung testen
Tatsächlich sind bei vielen Naturprodukten die Möglichkeiten der Vor- und Zwischenprodukte in der Biosynthese oft gar nicht bekannt.
Professor Greg Challis vom Fachbereich Chemie an der Universität Warwick und vom Biomedicine Discovery Institute an der Monash Universität sieht hier einen Paradigmenwechsel in der Antibiotikaforschung. So könnten zukünftig durch die Identifizierung und Untersuchung von Zwischenprodukten in den Stoffwechselwegen verschiedener Naturstoffe wirksame neue Antibiotika mit einer höheren Resilienz gegen Resistenzen gefunden werden, die im Kampf gegen Antimikrobielle Resistenzen (AMR) helfen werden.
Prämethylenomycin-C-Lacton: vielversprechendes Antibiotikum
In einer früheren Arbeit, publiziert im „Journal of Organic Chemistry“, haben Forschende der beiden Universitäten bereits einen skalierbaren Synthese-Weg für das mögliche neue Antibiotikum dargelegt. Das könne es ermöglichen, verschiedene Derivate und Analoga zu produzieren, um Wirkmechanismen und andere Parameter des Wirkstoffs genau zu erforschen und in entsprechende präklinische Forschungen einzutreten.
„Mit seiner einfachen Struktur, seiner starken Wirksamkeit, seinem kaum Resistenzen fördernden Profil und seiner skalierbaren Synthese stellt Prämethylenomycin-C-Lacton einen vielversprechenden neuen Kandidaten dar, der möglicherweise dazu beitragen könnte, einige der 1,1 Millionen Menschen zu retten, die jedes Jahr Opfer von AMR werden“, heißt es seitens der Forschenden.
Ob der Wirkstoff damit tatsächlich ein „Superantibiotikum gegen Superkeime“ darstellen kann, wird sich erst in fernerer Zukunft zeigen, wenn sich Prämethylenomycin-C-Lacton in klinischen Forschungen bewährt.
Was sich allerdings aus der Studie der Briten und Australier lernen lässt, ist, dass sich auf der Suche nach neuen Antibiotika auch der Blick auf vermeintlich Unfertiges in der Natur lohnen kann. Quellen:
https://cir.nii.ac.jp/crid/1390001204153057792
https://pubs.acs.org/doi/10.1021/jacs.5c12501
https://doi.org/10.1021/acs.joc.5c01179
https://warwick.ac.uk/news/pressreleases/new_antibiotic_for_drug_resistant_bacteria_found_hiding_in_plain_sight/